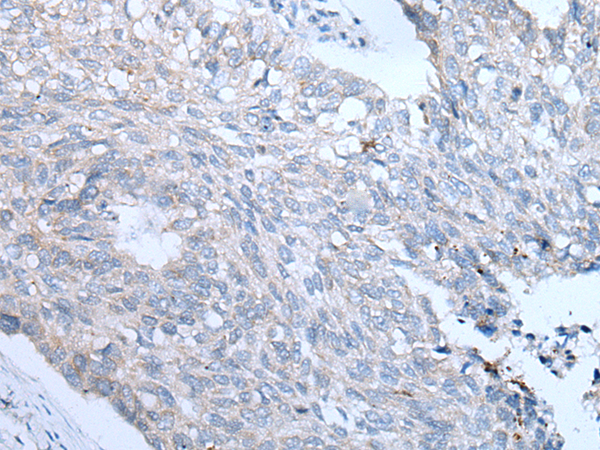

|
Background: |
The intracellular fatty acid-binding proteins (FABPs) belongs to a multigene family. FABPs are divided into at least three distinct types, namely the hepatic-, intestinal- and cardiac-type. They form 14-15 kDa proteins and are thought to participate in the uptake, intracellular metabolism and/or transport of long-chain fatty acids. They may also be responsible in the modulation of cell growth and proliferation. Fatty acid-binding protein 3 gene contains four exons and its function is to arrest growth of mammary epithelial cells. This gene is a candidate tumor suppressor gene for human breast cancer. |
|
Applications: |
ELISA, WB, IHC |
|
Name of antibody: |
FABP3 |
|
Immunogen: |
Synthetic peptide of human FABP3 |
|
Full name: |
fatty acid binding protein 3, muscle and heart |
|
Synonyms: |
MDGI; FABP11; H-FABP; M-FABP; O-FABP |
|
SwissProt: |
P05413 |
|
ELISA Recommended dilution: |
5000-10000 |
|
IHC positive control: |
Human brain and human lung cancer |
|
IHC Recommend dilution: |
25-100 |
|
WB Predicted band size: |
15 kDa |
|
WB Positive control: |
Human heart tissue |
|
WB Recommended dilution: |
200-1000 |

購物車
幫助
021-54845833/15800441009
